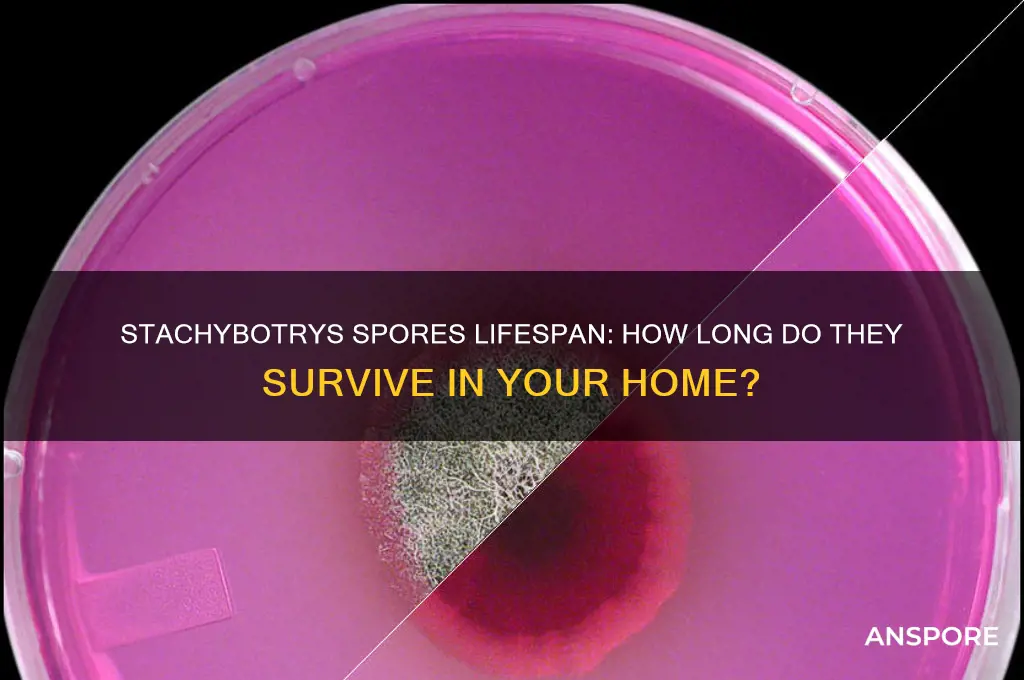
how long can stachybotrys spores last

Stachybotrys chartarum, commonly known as black mold, is a type of fungus notorious for its potential health risks and resilience. One of the most concerning aspects of this mold is the longevity of its spores, which can survive in a dormant state for extended periods under adverse conditions. Stachybotrys spores are highly resilient and can persist in environments with low humidity, extreme temperatures, and even after cleaning efforts that remove visible mold growth. Studies suggest that these spores can remain viable for years, waiting for favorable conditions such as increased moisture to germinate and re-establish colonies. Understanding how long Stachybotrys spores can last is crucial for effective mold remediation and prevention, as it highlights the importance of thorough cleanup and ongoing environmental control to mitigate health risks and prevent recurrence.
| Characteristics | Values |
|---|---|
| Survival Time in Ideal Conditions | Can remain viable for several years (e.g., in damp, cellulose-rich environments) |
| Survival Time in Dry Conditions | Can survive for months to years, but viability decreases over time |
| Temperature Tolerance | Survives in a wide range (4°C to 37°C), with optimal growth at 24°C to 32°C |
| Humidity Requirement | Requires high humidity (>90%) for growth, but spores can persist in lower humidity |
| Substrate Dependence | Thrives on cellulose-rich materials (e.g., paper, drywall, wood) |
| Resistance to Desiccation | Highly resistant to drying out, allowing spores to remain dormant |
| UV Light Resistance | Spores are moderately resistant to UV light but can be inactivated over time |
| Chemical Resistance | Resistant to many common disinfectants, requiring specialized removal methods |
| Airborne Persistence | Spores can remain suspended in air for extended periods, depending on conditions |
| Viability in Water | Can survive in water for weeks to months, depending on temperature and nutrients |
Explore related products
What You'll Learn
- Spores in Air: Stachybotrys spores can remain airborne for several hours to days
- Surface Survival: Spores persist on surfaces for months to years in ideal conditions
- Humidity Impact: High humidity prolongs spore viability, while dry conditions reduce lifespan
- Temperature Effects: Spores survive longer in cooler temperatures; heat accelerates decay
- Material Influence: Porous materials (e.g., wood, drywall) allow spores to last longer

Spores in Air: Stachybotrys spores can remain airborne for several hours to days
Stachybotrys spores, often associated with water-damaged buildings, can linger in the air far longer than one might expect. These microscopic particles, once released from their mold colonies, can remain suspended for several hours to days, depending on environmental conditions. This airborne persistence poses a significant health risk, as prolonged exposure can lead to respiratory issues, allergies, and in severe cases, toxic effects. Understanding their longevity in the air is crucial for anyone dealing with mold contamination, as it directly impacts the effectiveness of remediation efforts and the safety of occupants.
The duration Stachybotrys spores stay airborne is influenced by factors such as humidity, temperature, and air movement. In high-humidity environments, spores absorb moisture, becoming heavier and settling more quickly. Conversely, in dry conditions, they remain lighter and can float indefinitely until they encounter a surface. Air circulation also plays a critical role; stagnant air allows spores to accumulate, while ventilation disperses them, potentially spreading contamination to other areas. For instance, using fans during mold cleanup can inadvertently aerosolize spores, increasing airborne concentrations and prolonging their presence in the air.
Practical steps can mitigate the risks associated with airborne Stachybotrys spores. During remediation, it’s essential to use HEPA-filtered air scrubbers to capture spores and prevent their recirculation. Sealing off contaminated areas with plastic sheeting and negative air pressure systems can contain spores, minimizing their spread. For individuals sensitive to mold, such as those with asthma or compromised immune systems, wearing N95 respirators is advisable when entering affected spaces. Regularly monitoring indoor air quality post-remediation ensures spore levels return to safe thresholds, typically below 1,000 spores per cubic meter of air.
Comparatively, Stachybotrys spores differ from other common indoor mold spores, such as Aspergillus or Penicillium, in their weight and moisture affinity. Their heavier nature means they settle faster under certain conditions, but their ability to remain airborne for extended periods still makes them a persistent threat. Unlike lighter spores that may travel farther, Stachybotrys spores tend to concentrate in localized areas, making targeted remediation more feasible but equally critical. This distinction highlights the importance of tailored strategies when addressing Stachybotrys contamination.
In conclusion, the airborne longevity of Stachybotrys spores demands a proactive and informed approach to mold management. By understanding the factors that influence their persistence and implementing specific mitigation techniques, individuals can effectively reduce exposure risks. Whether dealing with a small residential issue or a large-scale commercial problem, recognizing the unique behavior of these spores in the air is key to creating a safer, healthier environment.
Mold Spores and Lung Health: Uncovering the Hidden Risks
You may want to see also

Surface Survival: Spores persist on surfaces for months to years in ideal conditions
Stachybotrys spores, often associated with water-damaged buildings, are remarkably resilient. Under ideal conditions—low light, high humidity, and stable temperatures—these spores can persist on surfaces for months to years. This longevity is not just a theoretical concern; it has practical implications for homeowners, property managers, and anyone dealing with mold remediation. Understanding this survival capability is crucial for effective prevention and cleanup strategies.
Consider the environment where Stachybotrys thrives: damp, dark spaces like basements, attics, or behind walls. In such settings, spores can remain dormant yet viable, waiting for the right conditions to germinate. For instance, a single spore on a wooden beam in a humid basement could remain a threat for years, reactivating if moisture levels rise. This persistence underscores the importance of not just removing visible mold but also addressing the underlying conditions that allow spores to survive.
To combat this, proactive measures are essential. Regularly inspect areas prone to moisture accumulation, such as under sinks, around windows, and in crawl spaces. Use dehumidifiers to maintain indoor humidity below 50%, as higher levels create an ideal environment for spore survival. When cleaning, avoid dry brushing or sweeping, which can disperse spores into the air. Instead, use damp cloths or HEPA-filtered vacuums to trap spores effectively. For surfaces where spores may have settled, a solution of detergent and water or a mold-specific cleaner can help eliminate them.
Comparatively, Stachybotrys spores outlast many other mold types due to their thick cell walls, which provide protection against harsh conditions. While some molds may degrade within weeks, Stachybotrys’ resilience demands a more rigorous approach. For example, while Aspergillus spores might survive for months, Stachybotrys can outlast them by years in the same environment. This distinction highlights the need for tailored remediation strategies when dealing with Stachybotrys.
Finally, the takeaway is clear: surface survival of Stachybotrys spores is not a short-term issue. Their ability to persist for extended periods means that prevention and thorough cleanup are non-negotiable. Ignoring this can lead to recurring mold problems and potential health risks, such as respiratory issues or allergic reactions. By understanding and addressing the conditions that allow spores to thrive, you can protect both your property and your health.
Can You Buy Magic Mushroom Spores at Garden Centers?
You may want to see also

Humidity Impact: High humidity prolongs spore viability, while dry conditions reduce lifespan
Stachybotrys spores, commonly associated with black mold, exhibit a striking sensitivity to humidity levels, which directly influences their longevity. In environments with relative humidity above 70%, these spores can remain viable for several months, even years, under optimal conditions. Conversely, in dry settings where humidity drops below 50%, their lifespan diminishes significantly, often to a matter of days or weeks. This stark contrast underscores the critical role moisture plays in spore survival, making humidity control a pivotal factor in mold management.
To mitigate the persistence of Stachybotrys spores, maintaining indoor humidity between 30% and 50% is essential. Dehumidifiers are invaluable tools in this effort, particularly in damp areas like basements, bathrooms, and kitchens. For instance, running a dehumidifier in a 500-square-foot basement can reduce humidity from 75% to 45% within 24 hours, effectively curtailing spore viability. Pairing this with proper ventilation, such as using exhaust fans during showers or cooking, further disrupts the humid conditions spores thrive in.
A comparative analysis reveals that high humidity not only sustains spores but also accelerates mold growth, compounding the problem. In a study, Stachybotrys spores exposed to 80% humidity colonized surfaces within 5 days, whereas those in 40% humidity showed no growth after 14 days. This highlights the dual threat of humidity: it prolongs spore life and fosters rapid mold proliferation. Conversely, dry conditions act as a double-edged sword, weakening spores but potentially aerosolizing them, increasing inhalation risks. Thus, while dryness reduces viability, it necessitates careful cleanup to avoid spore dispersal.
Practical tips for homeowners include monitoring humidity with hygrometers, which cost as little as $10, and addressing water leaks promptly, as even minor moisture accumulation can elevate humidity levels. In regions with naturally high humidity, such as coastal areas, investing in whole-house dehumidification systems may be warranted. Additionally, storing susceptible materials like cardboard and fabric in dry, sealed containers prevents them from becoming spore reservoirs. By understanding and manipulating humidity, individuals can significantly curtail the lifespan of Stachybotrys spores, safeguarding both property and health.
Do Spores Have Mitochondria? Unraveling the Mystery of Cellular Energy
You may want to see also
Explore related products

Temperature Effects: Spores survive longer in cooler temperatures; heat accelerates decay
Stachybotrys spores, often associated with black mold, exhibit a striking sensitivity to temperature, which directly influences their longevity. In cooler environments, typically below 68°F (20°C), these spores can remain viable for years, lurking in dormant states until conditions favor growth. This resilience in low temperatures is a survival mechanism, allowing them to persist in dormant states until they encounter moisture and organic material to feed on. For instance, spores in unheated basements or storage areas can survive indefinitely, posing a latent threat to indoor air quality.
Conversely, heat acts as a formidable adversary to Stachybotrys spores. Temperatures above 140°F (60°C) can rapidly degrade their cellular structure, rendering them non-viable within minutes. This principle is leveraged in professional mold remediation, where heat treatment is often employed to eradicate spores from contaminated materials. For homeowners, maintaining indoor temperatures above 75°F (24°C) can discourage spore germination, though it won’t eliminate existing spores entirely. A practical tip: use a dehumidifier in conjunction with heating to create an environment hostile to both spore survival and growth.
The interplay between temperature and humidity further complicates spore longevity. While cooler temperatures extend survival, high humidity (above 60%) can counteract the benefits of heat by providing the moisture spores need to thrive. For example, a warm but humid bathroom may still foster spore growth despite elevated temperatures. To mitigate this, aim for a relative humidity below 50% in areas prone to mold, such as kitchens and bathrooms, and ensure proper ventilation to expel moist air.
Understanding temperature effects on Stachybotrys spores is crucial for prevention and control. For long-term storage of items susceptible to mold, such as books or clothing, keep them in climate-controlled spaces where temperatures remain consistently above 70°F (21°C) and humidity is regulated. In contrast, short-term exposure to extreme heat, such as during laundry drying or surface cleaning with steam, can effectively neutralize spores on contact. By manipulating temperature strategically, you can disrupt the spore lifecycle and reduce the risk of mold-related health issues.
Can Mold Spores Penetrate Walls? Uncovering the Truth Behind Airborne Movement
You may want to see also

Material Influence: Porous materials (e.g., wood, drywall) allow spores to last longer
Stachybotrys spores, commonly associated with black mold, can persist in environments for extended periods, but their longevity is significantly influenced by the materials they inhabit. Porous materials like wood, drywall, and ceiling tiles act as ideal hosts, allowing spores to embed deeply and remain dormant until conditions favor their growth. This characteristic makes porous surfaces particularly problematic in mold remediation efforts, as surface cleaning alone often fails to eliminate the threat.
Consider the structural composition of these materials. Wood, for instance, contains natural fibers and air pockets that trap moisture and spores, creating a microenvironment conducive to survival. Drywall, though seemingly solid, is highly absorbent and can wick moisture from one area to another, spreading spores throughout a building. In a study by the Environmental Protection Agency (EPA), spores on wood surfaces were found to remain viable for up to 20 years under dry conditions, reactivating once moisture levels increased. This underscores the importance of not only removing visible mold but also addressing the material itself during remediation.
From a practical standpoint, homeowners and professionals must adopt a targeted approach when dealing with porous materials. For example, if mold is detected on drywall, cutting out and replacing the affected area is often more effective than attempting to clean it. Wood surfaces may require sanding or sealing to remove embedded spores, though severely infested materials should be discarded. Using HEPA vacuums and antimicrobial treatments can further reduce spore viability, but these measures are most effective when combined with material removal or replacement.
Comparatively, non-porous materials like glass or metal offer little refuge for spores, which typically remain on the surface and are easily removed with cleaning. This contrast highlights why porous materials demand specific attention in mold management. For instance, in flood-damaged homes, wood flooring and drywall are often the first to harbor persistent spore colonies, even after visible mold is addressed. Understanding this material-specific behavior can guide more effective prevention and remediation strategies.
In conclusion, the longevity of Stachybotrys spores on porous materials is a critical factor in mold control. By recognizing how these materials facilitate spore survival, individuals can take proactive steps to mitigate risks. Whether through material replacement, thorough cleaning, or moisture management, addressing the unique challenges posed by porous surfaces is essential for maintaining a mold-free environment.
Abducting Epic Spores: Myth or Reality in Gaming Explained
You may want to see also
Frequently asked questions
Stachybotrys spores can survive in the environment for many years, especially in dry conditions, as they are highly resilient and can remain dormant until favorable conditions for growth return.
While some spores may degrade over time, many Stachybotrys spores retain their viability for extended periods, particularly in protected environments like within building materials or under low humidity.
Yes, dormant Stachybotrys spores can become active and produce mycotoxins when conditions are right, potentially causing health issues such as respiratory problems, allergies, and other symptoms if inhaled or exposed to.





























